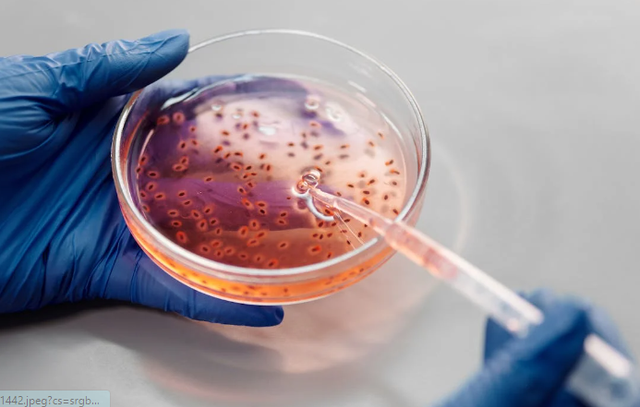
Ilustrasi contoh bioteknologi di bidang peternakan. Sumber: Pexels/Edward Jenner

4 Contoh Bioteknologi di Bidang Peternakan

Ragam Info
ยทwaktu baca 2 menit
Tulisan dari Ragam Info tidak mewakili pandangan dari redaksi kumparan
Bioteknologi telah membawa perubahan dalam industri peternakan. Terdapat beberapa contoh bioteknologi di bidang peternakan yang meningkatkan produktivitas hasil ternak.
Dikutip dari Buku Solusi Sukses Belajar Biologi SMP/MTs, Lucius Bekti Sulistyo D.P. dkk, (hal. 143), bioteknologi adalah pemanfaatan makhluk hidup atau bahan yang diperoleh dari makhluk hidup untuk menghasilkan suatu produk atau jasa bermanfaat bagi manusia.
4 Contoh Bioteknologi di Bidang Peternakan
Dalam bidang ilmu sains dipelajari contoh bioteknologi di bidang peternakan. Berikut daftar contohnya.
1. Kloning
Kloning merupakan proses menghasilkan salinan genetik yang identik dari suatu entitas biologi. Kloning ini berasal dari bahasa Yunani, yaitu klonus atau kloon yang berarti ranting, tunas, atau cangkok.
Di bidang peternakan, kloning sudah diperkenalkan sejak tahun 1900, namun penerapannya baru mulai dipraktikkan pada tahun 1996. Di tahun 1997, sapi jantan bernama Gene berhasil dikloning oleh infigen Inc dari sebuah sel fetus.
Kloning ini bermanfaat untuk upaya pelestarian hewan-hewan yang hampir punah.
2. Hormon Buatan
Sama seperti manusia, hewan juga membutuhkan hormon untuk membantu kinerja organ dan juga sistem organ di dalam tubuhnya. Hormon buatan manusia diberikan kepada hewan ternak supaya dapat meningkatkan produksi susu atau pembentukan daging di dalam tubuhnya.
Produk bioteknologi hormon buatan untuk hewan ini biasanya dibuat menggunakan teknologi DNA rekombinan. Di mana tekniknya dimulai dengan mengisolasi DNA, memotong DNA, menggabungkan DNA, dan juga memasukkan DNA ke dalam sel hidup.
3. Vaksin
Selanjutnya, vaksin. Dalam dunia kesehatan, vaksin dimanfaat untuk mencegah terjadinya infeksi bakteri atau virus di dalam tubuh organisme hidup.
Vaksin juga digunakan pada hewan-hewan ternak untuk memberikan kekebalan tubuh pada ternak supaya dapat melawan penyakit.
4. Inseminasi Buatan
Inseminasi buatan merupakan contoh produk bioteknologi peternakan yang memiliki tujuan untuk melakukan perkembangbiakan pada hewan.
Selain itu, inseminasi buatan juga memiliki tujuan lain, yaitu:
Untuk meningkatkan mutu hewan ternak lokal.
Untuk mempercepat peningkatan populasi hewan ternak.
Untuk mendukung adanya perkawinan silang antar hewan dair berbagai ras.
Untuk mencegah adanya penularan penyakit kelamin pada hewan ternak.
Baca juga: Mengenal Biomagnetik dalam Ilmu Sains dan Contohnya
Itulah empat contoh bioteknologi di bidang peternakan. Semoga memberikan wawasan baru tentang ilmu sains. (ERI)
